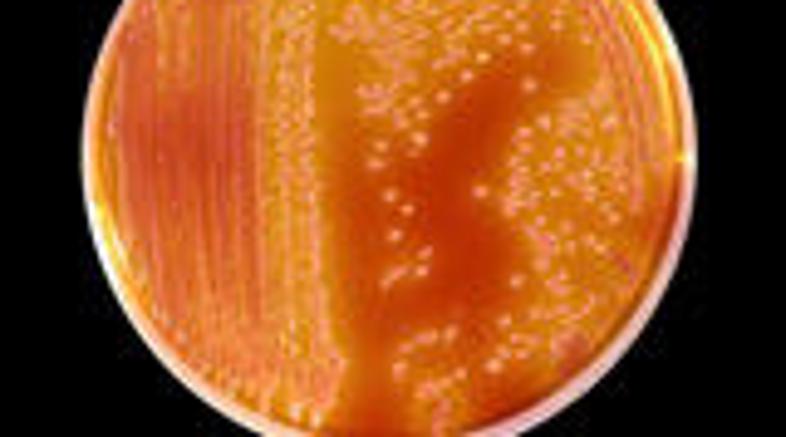

Umrli novorojenček se je pred dvema tednoma predčasno rodil v bolnišnici Heartsland v Birminghamu.
Skupaj s še enim otrokom sta se okužila z bakterijo Serratia, poročajo britanski mediji.
Zaposleni v bolnišnici Bordesley Green upajo, da bo drugi otrok lahko zapustil bolnišnico v
naslednjih nekaj tednih, je povedala predstavnica bolnišnice. Pet ostalih novorojenčkov, pri
katerih so bakterijo našli na njihovi koži, so preventivno dali v izolacijo, je še dodala
predstavnica bolnišnice.
Direktorica bolnišnice
Lisa Dunn je povedala:
"Serratia je organizem, ki se na vsake toliko časa pojavi na porodniških oddelkih bolnišnic. Da
bi preprečili razširjanje okužbe, smo začasno že zaprli porodniški oddelek."
Umrl zaradi smrtonosne bakterije
En novorojenček je umrl, šest pa jih je v izolaciji zaradi smrtonosne bakterije, ki so jo našli na porodniškem oddelku bolnišnice v Birminghamu.




